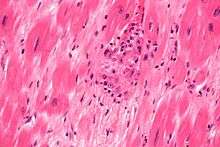

Aschoff cell
H&E stain with visible Aschoff cells in rheumatic heart disease.
In pathology, Aschoff (or Aschoff giant cells) cells are often cells associated with rheumatic heart disease. They are found in Aschoff bodies surrounding centres of fibrinoid necrosis.
In comparison with Anitschkow cells their cytoplasm is more basophilic, can contain more up to 4 nuclei.[1]
Aschoff believed that Aschoff giant cells were some type of connective or endothelial tissue.[2] Today are Aschoff cells considered to be derived from cardiac myocytes rather than connective tissue cells.[1]
Aschoff cells were named after the German physician and pathologist Ludwig Aschoff.
References
- 1 2 Aschoff Body. [online]. [cit. 2014-02-25]. Retrieved from http://www.histopathology-india.net/Asch.htm
- ↑ MCGUIRE, John. W. a Bernice G. WEDUM. ORIGIN OF THE ASCHOFF BODY. [online]. [cit. 2014-02-25]. Retrieved from http://ard.bmj.com/content/22/3/127.full.pdf
This article is issued from Wikipedia - version of the 5/2/2014. The text is available under the Creative Commons Attribution/Share Alike but additional terms may apply for the media files.